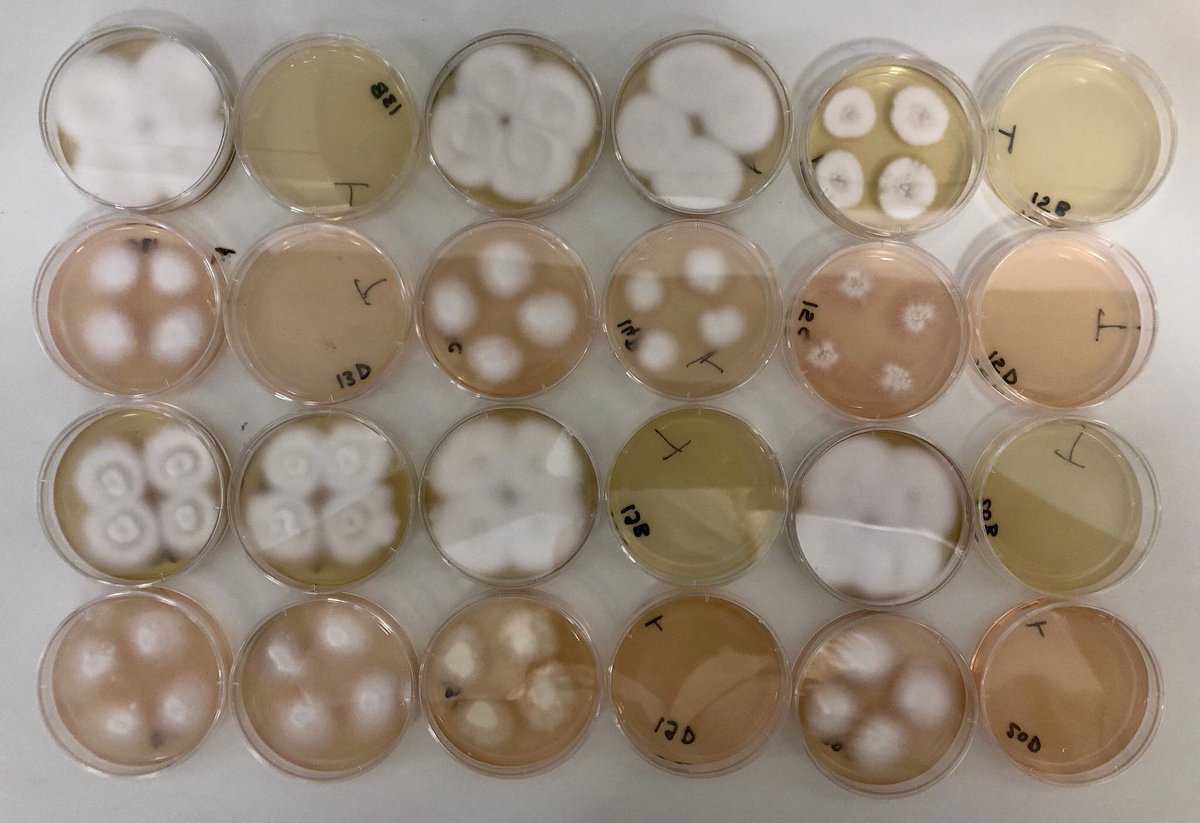
Sarah Dellière is on Bluesky 🦋 tweet media

Anne Haglund
560 posts

@DOC_ANH
Clinical microbiologist, from Aarhus, Denmark. #ClinicalMicrobiology #ID #Doc #CBRNE #virology

Reliability of a terbinafine agar containing method for the screening of dermatophyte resistance #MedicalMycology by @sarah_delliere & colleagues @ISHAM_Mycology doi.org/10.1093/mmy/my…



【Bacteremia associated with colorectal cancer】 CID Nov 2022 🇩🇰 45,774 bacteremia, 10-year cohort 👉bovis group streptococci 👉C. septicum 👉Bacteroides ovatus 👉Bacteroides uniformis 👉Clostridium tertium 👉Fusobacterium spp. 👉Gram-positive anaerobic cocci












Monkeypox alert in Spain after eight men show symptoms theguardian.com/world/2022/may…


.@Region_Midts nu tidligere koncerndirektør Ole Thomsen har forhandlet sig frem til to års løn plus pension udover en opsigelse på 12 måneder. De i alt tre årslønninger resulterer i en udgift på 6.489.314 kroner #sundpol buff.ly/3FTwuFV


